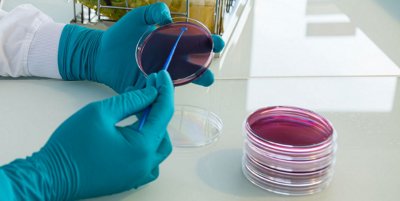
GENE-UP® Pathogenic E. coli

IDEA™ STEC
IMMUNODETECTION EVOLUTION AGAR
IDEA™ STEC is a patented and innovative culture media solution designed to simplify and enhance confirmation of Shiga toxin-producing E. coli (STEC), a major health issue.
bioMérieux’s solution is the first on the market allowing for the identification of Shiga toxin production as a link to pathogenicity.
This state-of-the-art technology delivers accurate results with fewer unconfirmed positives.

- Overview
- Get Started Today
A New Era for the Detection of Shiga Toxin-Producing E. coli
IDEA™ STEC is an advanced medium allowing the selective isolation of STEC strains and, more specifically, typical EHEC strains. IDEA™ STEC helps enhance confirmation workflows by making colony identification simpler, more reliable, and visually distinct.
In general, culture media used for selective isolation and identification are based on biochemical reactions. IDEA™ STEC allows you to start your search with deeper precision by directly targeting stx-positive colonies.

Download Product Fact Sheet
- Filename
- 26-IDEA-STEC-Agar-US-PRINT-V5.pdf
- Size
- 3 MB
- Format
- application/pdf
IDEA™ STEC allows Shiga toxin to halo, creating a clear visual indicator for presumptive STEC
Simplify Confirmation & Enhance Decision Making
- The simple, streamlined workflow allows for faster identification, resulting in informed risk assessments
- When used in combination with VIDAS® ESPT2, allows isolation of toxigenic TOP 7 serogroups (O157, O26, O111, O145, O103, O45 and O121)
- Maximizes detection confidence by rapidly pinpointing true positives with clear, visible colonies
Combat EHEC In Your Operation
bioMérieux offers a variety of solutions for pathogenic E. coli to cover your risk assessment and align with local regulatory requirements. Enhance your operation by avoiding unnecessary product hold, scrap, or diversion.
Wherever you operate, bioMérieux has you covered. Explore our end-to-end EHEC detection and confirmation portfolio and get in touch with our team to identify the solution best suited for your unique needs.
Be a Part of the Culture Media Evolution
Get in touch with our team using the form below and one of our experts will be in touch with details on IDEA™ STEC using the contact information you provide. By providing your information, you agree to receive additional emails from bioMérieux about STEC/EHEC detection.
To find out more about the management of your personal data and to exercise your rights, see our privacy policy.


